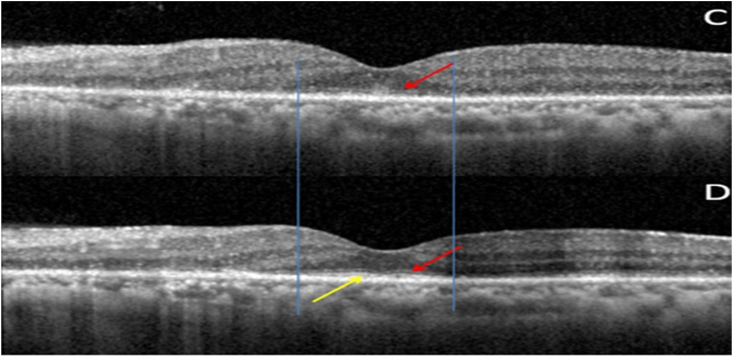
Fig. 7

Abstract
Purpose
Cancer-associated retinopathy (CAR) is a potentially blinding condition that can be stalled or,rarely, reversed if diagnosed early. This case report aims to highlight the role of Electroretinography (ERG) and Optical Coherence Tomography (OCT) in diagnosis and predicting treatment response, in the clinical scenario of unexplained vision loss in a patient with a recent diagnosis of uterine malignancy.
Observations
A 70 year old lady, recently diagnosed with Endometrial carcinoma Stage 3, came to us with defective vision and photopsiae of both eyes of ten days duration. A high index of suspicion, flat ERG, OCT changes, absence of metastasis, and positive Antirecoverin antibody clinched the diagnosis. Early systemic steroid therapy along with surgical removal of the tumour, adjuvant radiotherapy and chemotherapy helped in visual improvement in our patient.
Conclusions
Presence of intact ellipsoid zone (EZ) and external limiting membrane (ELM) in pre-treatment OCT was found to be a positive predictor of visual recovery.
Keywords: Cancer-associated retinopathy(CAR), Electroretinography(ERG), Optical coherence tomography(OCT), Fundus auto fluorescence(FAF), Ellipsoid zone(EZ), External limiting membrane(ELM)
1. Introduction
Cancer-associated retinopathy (CAR) is an autoimmune, paraneoplastic retinopathy characterized by sudden visual disturbance, electroretinographic (ERG) abnormalities, and retinal tissue loss; associated with a distant neoplasm.1, 2, 3 Classically, patients commonly complain of flickering lights, reduced visual acuity, colour impairment and photosensitivity. Diagnosis of CAR is made by exclusion of metastasis, and radionecrosis as causes of visual loss, with an attenuated ERG and detection of autoantibodies against retinal cell antigens.4 It is a potentially blinding condition that can be stalled or,rarely, reversed if diagnosed early.3
2. Case report
A 70 year old lady, incidentally detected to have an endometrial carcinoma Stage 3 on an executive check up, came to us with defective vision and photopsiae of both eyes of ten days duration. She was asymptomatic otherwise and thus had not taken any treatment for her gynaecological condition. Initial visual acuity was 20/80 (distance),20/200 (near) in both eyes. Pupils were sluggish binocularly; however there was no relative afferent pupillary defect. Colour vision was impaired (0/21 both eyes). Fundus was unremarkable except retinal pigment epithelium mottling at the macula.(Figure-1). Visual fields were severely depressed in both eyes (Fig. 2, Fig. 3). Magnetic Resonance Imaging (MRI)of the Brain & Orbits were normal; with no evidence of metastasis. All investigations including laboratory tests for posterior uveitis and vasculitis were done and were negative. Visual acuity worsened to Counting fingers close to face both eyes the next day. Fundus Auto Fluorescence (FAF) showed patchy hyperautofluorescence in both eyes (Figure-4). OCT Macula showed diffuse loss of ellipsoid zone (EZ), external limiting membrane (ELM), outer nuclear and plexiform layers in both eyes, except subfoveally; where EZ and ELM were faintly visible (Fig. 6, Fig. 7). Visually Evoked Potentials (VEP) both eyes showed poor waves with normal P2 latency. Electroretinography (ERG) both eyes revealed flat scotopic and photopic responses (Fig. 8, Fig. 9). Intravenous methylprednisolone 1g for 5 days was administered followed by oral steroids. Vision improved to 20/25 (distance),20/40 (near) in right eye and 20/40 (distance), 20/40 (near)in left eye respectively. Diagnosis of Cancer Associated Retinopathy (CAR) was confirmed by detection of Antirecoverin antibody (Athena Diagnostics, MA 01752,USA). Patient underwent Endometrial carcinoma surgery (Staging laparotomy with Total hysterectomy + Bilateral Salpingo-oopherectomy + removal of tumour with pelvic and para-aortic lymphnodes), radiotherapy and chemotherapy and is currently on maintenance dose of oral steroids. FAF on follow up (after 6 weeks of systemic steroid therapy) showed diffuse area of hypoautoflourescene; indicating the area of damaged retinal pigment epithelium about 1disc diameter beyond the arcades in both eyes (Figure-5). Follow up OCT of macula showed clear reappearance of ellipsoid zone (EZ) and external limiting membrane (ELM) subfoveally, where it was faintly visible previously; explaining the improvement in vision.(Fig. 6, Fig. 7); however there was no evidence of ellipsoid zone (EZ)and external limiting membrane (ELM) in the areas deficient pre-treatment. Correlating the macular hypoautoflurescence on FAF at follow up with macular OCT, we found persistent diffuse loss of outer retinal layers (ellipsoid, ELM, ONL, OPL) in both eyes. The ONL and OPL loss was more significant temporally than nasally, probably emphasising the need for careful examination of temporal retina to detect early outer retinal involvement. ERG responses continued to be grossly reduced in both eyes even after visual recovery.
Fig. 1.
Multicolour Fundus Picture Both eyes.
Fig. 2.
Visual Field Right eye.
Fig. 3.
Visual Field Left eye.
Fig. 4.
Fundus Auto Fluorescence before treatment showing patchy hyperautofluorescence.
Fig. 6.
(A): OD OCT Macula pre treatment showing diffuse loss of outer retinal layers (ellipsoid,ELM,ONL,OPL); more temporally. Sub-foveally faint ELM (red arrow)with isoreflectivity (yellow arrow) between ELM & RPE. (B): OD OCT Macula post treatment showing persistent diffuse loss of outer retinal layers. Sub-foveally faint ELM +(red arrow) with reappearance/reorganised ellipsoid layer (yellow arrow). Vertical blue lines depict the reappearance/reorganisation of EZ in the areas were ELM was present pre-treatment. (For interpretation of the references to colour in this figure legend, the reader is referred to the Web version of this article.)
Fig. 7.
(C): OS OCT Macula pre treatment showing diffuse loss of outer retinal layers (ellipsoid, ELM,ONL, OPL). ONL and OPL intact nasally. Subfoveally faint ELM present (red arrow). 7(D): OS OCT Macula post treatment showing persistent diffuse loss of outer retinal layers (ellipsoid, ELM, ONL, OPL). Subfoveally faint ELM (red arrow) with reappearance/reorganised ellipsoid layer (yellow arrow) is seen. Vertical blue lines depict the reappearance/reorganisation of EZ in the areas were ELM was present pre-treatment. (For interpretation of the references to colour in this figure legend, the reader is referred to the Web version of this article.)
Fig. 8.
FFERG OD showing severely diminished scotopic and photopic responses.
Fig. 9.
FFERG OS showing severely diminished scotopic and photopic responses.
Fig. 5.
Fundus Auto Fluorescence post treatment showing diffuse area of hypoautoflurescene (beyond the blue marking) corresponding to the areas of damaged RPE. (For interpretation of the references to colour in this figure legend, the reader is referred to the Web version of this article.)
3. Discussion
Cancer-associated retinopathy (CAR); a type of autoimmune retinopathy (Table 1)5, is characterized by rapid visual deterioration in the setting of a distant neoplastic process, without another identifiable cause. Retinal examination may appear normal or reveal mild disc pallor, arteriolar narrowing, chorioretinal or retinal pigment epithelial atrophy.5 Several studies have shown that the tumours aberrantly express proteins normally exclusive to retinal tissue, leading to the production of antibodies directed against these retinal antigens; resulting in retinal degeneration. The most common antigen associated with CAR is recoverin.6 Recoverin is a 23 kD calcium binding protein normally found in retinal photoreceptor cells that are involved in the transduction of light. Untreated,anti-recoverin associated CAR will progress to severe vision loss, often to no light perception. Prompt recognition and early initiation of therapy is critical for vision preservation and may improve patients’ quality of life.2 Specific anti-tumour therapy (i.e.surgery, chemotherapy, and/or radiation) along with corticosteroids or immunosuppressives/intravenous immunoglobulin have been used with mixed results.4,5
Table 1.
(Taken from “management of autoimmune retinopathies with Immunosuppression.Arch Ophthalmol.2009; 127 (4):390–397.Henry.A.Ferreyra, Thiran Jayasundera, Naheed W.Khan, Shirley He,Ying,Lu, John R. Heckenlively”.5
| DIAGNOSTIC CRITERIA FOR AUTOIMMUNE RETINOPATHY5 | ||
|---|---|---|
| Strong Evidence | Supportive Evidence | Helpful Evidence |
| Diffuse retinal atrophy | Abnormal ERG, typical symptoms, no pigment deposits | Anti-arrestin antibody |
| Severely diminished/extinguished a and b waves, negative waves in ERG | Sudden onset of photopsias; prev normal VA | Anti -enolase antibody |
| Antirecoverin antibody | Rapid progression by history or visual fields | No family h/o of RP |
| Response to trial of Methylprednisolone | Multiple antiretinal anibody bands on Western blot testing | |
| CME in panretinal degeneration | Family h/o of autoimmune disease | |
| Family h/o of autoimmune disease | ||
| H/o autoimmune disease in 50% of immediate family | ||
4. Conclusions
This report aims to highlight Cancer-associated retinopathy (CAR); a potentially blinding condition with a guarded prognosis. A high index of suspicion, flat ERG, OCT changes, absence of metastasis, and positive Antirecoverin antibody clinched the diagnosis. Early systemic steroid therapy along with surgical removal of the tumour and adjuvant radiotherapy and chemotherapy helped in visual improvement in our patient. Presence of intact ellipsoid zone (EZ) and external limiting membrane (ELM) in pre-treatment OCT was found to be a positive predictor of visual recovery.
References
- 1.Sawyer R.A., Selhorst J.B., Zimmerman L.E., Hoyt W.F. Blindness caused by photoreceptor degeneration as a remote effect of cancer. Am J Ophthalmol. 1976;81(5):606–613. doi: 10.1016/0002-9394(76)90125-2. [DOI] [PubMed] [Google Scholar]
- 2.Klingele T.G., Burde R.M., Rappazzo J.A. Paraneoplastic retinopathy. J Clin Neuro Ophthalmol. 1984;4(4):239–245. [PubMed] [Google Scholar]
- 3.Shildkrot Yevgeniy, Sobrin Lucia, Evangelos S. Gragoudas.Cancer-Associated retinopathy:update on Pathogenesis&Therapy. Semin Ophthalmol. 2011;26(4-5):321–328. doi: 10.3109/08820538.2011.588657. [DOI] [PubMed] [Google Scholar]
- 4.Guy J., Aptsiauri N. Treatment of paraneoplastic visual loss with intravenous immunoglobulin: report of 3 cases. Arch Ophthalmol. 1999;117:471–477. doi: 10.1001/archopht.117.4.471. [DOI] [PubMed] [Google Scholar]
- 5.Ferreyra HenryA., Jayasundera Thiran, Khan Naheed W., He Shirley, Lu Ying, Heckenlively John R. Management of autoimmune Retinopathies with immunosuppression. Arch Ophthalmol. 2009;127(4):390–397. doi: 10.1001/archophthalmol.2009.24. [DOI] [PubMed] [Google Scholar]
- 6.Thirkill C.E., Tait R.C., Tyler N.K., Roth A.M., Keltner J.L. The cancer-associated retinopathy antigen is a recoverin-like protein. Invest Ophthalmol Vis Sci. 1992;33(10):2768–2772. [PubMed] [Google Scholar]